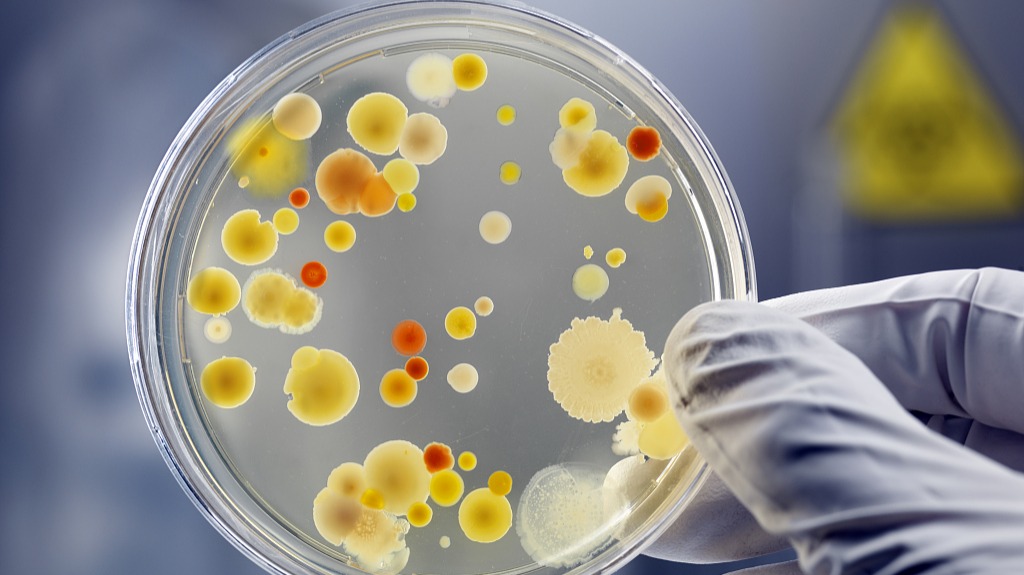

扫码打开虎嗅APP
本文转自微信公众号:我是科学家iScientist(ID:IamaScientist),作者:Nekout,头图来自:视觉中国。
现今,细菌耐药性的问题已经引起人们的高度关注,各种“超级细菌”的出现似乎又要把我们推向一个“无药可救”的时代。
就在一百年前,很轻微的感染就可能把一个成年人送入坟墓。还好弗莱明发现了抗生素,改变了这一切,进而提高了人类的平均寿命。于是,抗生素渐渐普及,它们种类繁多又廉价方便,被频繁地用在医药和畜牧领域。
然而,近些年,新的问题暴露出来——抗生素的滥用无形中促进了细菌的进化,人们逐渐发现,以前好用的抗生素,似乎越来越难与新产生的超级细菌相对抗。

细菌的药敏实验。图中每个白色小圆片中包含一种类型的抗生素,左边普通细菌无法在抗生素周围存活,而右边的超级细菌能够抵抗多种类型的抗生素。图片来源:wikimedia commons
由于新抗生素的研发和应用速度远远追不上及细菌产生新的耐药性的步伐,人们不得不想出其他的办法来解决这个问题。
其中一种方案,就是利用噬菌体——这个天然细菌杀手,来对抗超级细菌。
噬菌体(Bacteriophage),是一种只杀细菌的微小病毒。他的多面体头部里面包含着噬菌体的遗传物质(通常是一段单链的DNA),头部紧连着一个带有多条蛋白纤维腿的长尾巴。地球上噬菌体的数量要远远超过其他所有物种数量的总和,分布于世界上的任意一个角落。

有些噬菌体,如肌尾噬菌体科(Myoviridae)噬菌体,看起来就像是一个精巧的机器人。原图来自wikimedia commons,本文作者汉化
噬菌体和细菌之间的战斗已经持续了数亿年。它们在我们肉眼不可见的微观世界中,每时每刻都上演着生死之争。
噬菌体很小,体积大约只有细菌的百分之一,但它们不仅“胃口大”,而且很“挑食”——通常一种噬菌体只对一种类型的细菌“情有独钟”。当噬菌体找到这个“专属猎物”时,它会将自己的遗传物质强行注射入细菌体内,把整个细菌变成自己后代的生产加工车间。当细菌内的资源消耗殆尽后,噬菌体会指挥细菌产生内溶素,从内部把细菌家的围墙(细胞壁)开个大口子,然后新生的噬菌体们一涌而出,愉快地去寻找新的猎物。

T4噬菌体侵染细菌的过程。原图来自wikimedia commons,本文作者汉化
但有些时候,噬菌体侵入细菌后,并不会立即展开进攻,而是渗入到细菌内部(基因组中)潜伏起来,这个过程被称为“噬菌体的溶原性”。在这段时间里,噬菌体会与细菌一起“同甘”,甚至度过几个世代。但不要指望它们和细菌“共苦”——当细菌受到一些外界的刺激(例如紫外照射或氧化应激),即将小命不保时,噬菌体又会立刻“原形毕露”,迅速制造出新的噬菌体并逃离濒死的细菌。

噬菌体的溶原和裂解循环。图片来源:Wikimedia common
2014年,美国洛克菲勒大学的一个研究团队在自然-生物技术杂志(Nature Biotechnology)上发表了一种经过人工改造后能以基因为靶向的噬菌体杀菌剂。他们通过基因工程方法将具有靶向于特定细菌基因组序列的CRISPR/Cas9系统导入噬菌体基因组中,生成的基因工程噬菌体能够特异性的识别并杀死具有某个特定基因的细菌。
这样一来就可以做到“指哪儿打哪儿”,实现在一个微生物群体中仅杀死特定目标病原菌,而不影响到其他有益菌的功效[1]。

噬菌体靶向杀菌剂的原理示意图。图片来源:参考文献[1]
看起来,噬菌体似乎可以成为人类对抗超级细菌的“好帮手”了,不过也别忙着下结论,就在近期,另一项发表在《科学》(Science)上新研究指出,噬菌体在杀菌过程中也可能参与细菌抗性基因的传播,从“帮手”变成“帮凶”[2]。
研究者们发现,在金黄色葡萄球菌(Staphylococcus aureus)中,有些正潜伏在细菌基因组中“同甘”的噬菌体(溶原性噬菌体),在受到外界环境刺激后,也会选择拒绝“共苦”。而且它们不仅要夺细菌的命,还要劫细菌的“财”——遗传物质。
这些噬菌体在细菌体内复制自己并包装新噬菌体的过程中,会有一定概率把一些细菌基因组中的DNA包装进自己的基因组,这些DNA中有些可能就是帮助细菌抵抗抗生素的“耐药基因”。这些耐药基因会随着新形成的噬菌体像发快递一样传递给其他细菌。
就好像蜜蜂在吸食花蜜时会沾染花粉帮助植物异化授粉一样,噬菌体在侵染并杀死细菌的同时,也扮演了帮助细菌进化、对抗抗生素的角色。看来,要用噬菌体来剿灭超级细菌,可能仍需谨慎而为之了。
本文转自微信公众号:我是科学家iScientist(ID:IamaScientist),作者:Nekout。